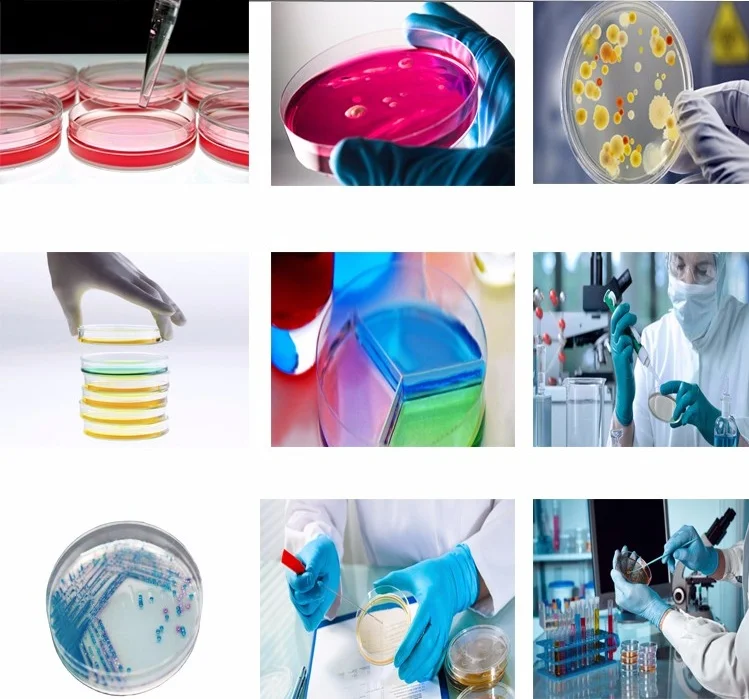
05-petri-dish.jpg
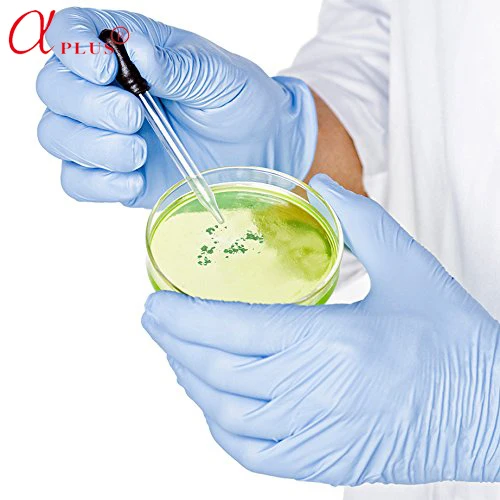
Лаборатории одноразовые пластиковые ps 35 60 65 70 90 150 мм чашки Петри

Лаборатории одноразовые пластиковые ps 35 60 65 70 90 150 мм чашки Петри
- Category: >>>
- Supplier: Qingdao Ama Co. Ltd.
Share on (1100010904403):
Product Overview
Description
Лаборатории одноразовые пластиковые ps 35 60 65 70 90 150 мм чашки Петри

Лаборатории одноразовые пластиковые ps 35 60 65 70 90 150 мм чашки Петри

Лаборатории одноразовые пластиковые ps 35 60 65 70 90 150 мм чашки Петри
| Описание | Материал | Кол-во/мешок | Кол-во/ctn |
| 35 мм * 15 ммПетри | PS | 20 | 2600 |
| 60 мм * 15 ммПетри | PS | 26 | 1040 |
| 65 мм * 15 ммПетри(Сетка номера) | PS | 20 | 1000 |
| 70 мм * 15 ммПетри | PS | 20 | 700 |
| 75 мм * 15 ммПетри(Уха) | PS | 10 | 360 |
| 90 мм * 15 ммПетри | PS | 10 | 500 |
| 90 мм * 15 ммПетри(Две решетки) | PS | 10 | 500 |
| 90 мм * 15 ммПетри(Три решетки) | PS | 10 | 500 |
| 90 мм * 20 ммПетри | PS | 15 | 375 |
| 150 мм * 15 ммПетри | PS | 10 | 180 |
Лаборатории одноразовые пластиковые ps 35 60 65 70 90 150 мм чашки Петри
Лаборатории одноразовые пластиковые ps 35 60 65 70 90 150 мм чашки Петри
Циндао индийское биохимическое оборудование co. Ltd
Циндао индийское биохимическое оборудование co., Ltd. Был основан в 1992 году и штаб-квартира в Тайване.
Компания обслуживает больницы, национальные исследовательские институты, лаборатории, университеты и продовольствие, фармацевтические компании, специализируюсь на разработке, производстве, маркетинге, международной торговле одноразовыми медицинскими расходными материалами.
Компания рассматривает качество продукции как корпоративную жизнь, В соответствии с международными стандартами системы качества установлен полный комплект строгой внутренней системы контроля качества, прошло iso9001, hl-Tech Corporation, ce сертификация, отличное качество продукции и высокая производительность, изготавливаем изделие с высокой конкурентоспособностью и высоким коэффициентом похвалы.
Компания имеет класс 10,000, 100,000 и 300,000 уровня очистки, мастер-классы, и представляет Полностью Автоматическую производственную линию и вакуумное производственное оборудование от Тайваня.
Одноразовые пластиковые 35 60 70 90*15 мм стерильные чашки Петри

Лаборатории одноразовые пластиковые ps 35 60 65 70 90 150 мм чашки Петри
| Получить цитату |
 |  |  |
| Пробирки | Пробирки | Пипетки |
 |  |  |
| Культура клеток плиты | Пример Кубка | Вакуумные пробирки |
We Recommend
New Arrivals
New products from manufacturers at wholesale prices